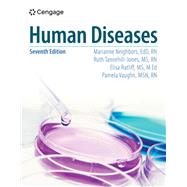

All Results
Showing Results 1 - 10 of 16
Sorting:
Buy New
$143.73
Bundle: Human Diseases, 6th + MindTap, 2 ...
ISBN: 9780357762691
Copyright:
Paperback w/ Access Card
Rent
$208.05
Due Date: 5/29/2026
Buy New
$149.25
Rent
$59.74
Due Date: 5/29/2026
Buy New
$63.30
Buy New
$114.67
Rent
$172.85
Due Date: 5/29/2026
Buy New
$183.90
Bundle: Human Diseases, 5th + MindTap Basic ...
ISBN: 9781337805940
Copyright:
Paperback w/ Access Card
Rent
$184.94
Due Date: 5/29/2026
Buy New
$196.76